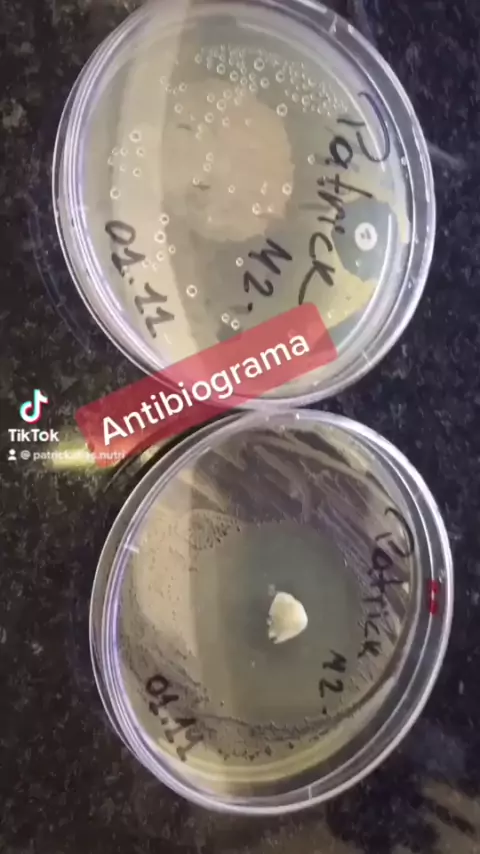

متابعة
27
0
10
Patrick.Dias.Nutri
Análise de hoje “Antibiograma.” Ação antibiótica da azitromicina (placa da esquerda) e Alho in natura (placa da direita) frente a cultura de “Staphilococcus.” #nutricao #MICROBIOLOGIA #filtrodocanarinho #laboratorio #jogoemcasa
المزيد
تقييم
إلغاء
إرسال